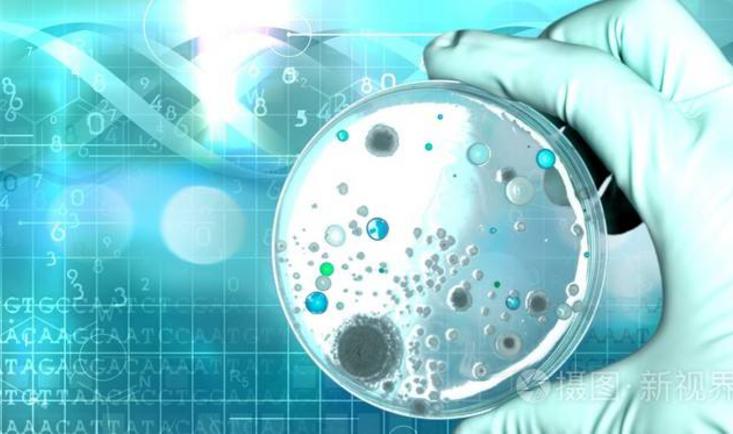

职称:副教授
单位:井冈山大学
部门:生命科学学院
主讲教师:廖永辉等
教师团队:共4位
| 学校: | 井冈山大学 |
| 开课院系: | 生命科学学院 |
| 专业大类: | 环境科学与工程 |
| 开课专业: | 环境工程 |
| 课程负责人: | 刘仁绿 |
| 课程英文名称: | Environmental Microbiology Experiment |
| 课程编号: | 08020513 |
| 学分: | 1 |
| 课时: | 32 |
环境工程微生物实验课程是培养未来环境科学工作者掌握有关环境微生物学基本实验方法和技能的一门必修课。其包括微生物制片及染色技术,观察培养微生物的方法,培养基的配制与灭菌,纯种分离与接种技术,微生物生长测定,微生物种的快速鉴定,环境监测中微生物学方法等10多个实验。
通过本课程的教学,不但使学生能熟悉环境中微生物的主要类群,牢固掌握环境微生物学实验的基本操作技能,而且也使学生初步掌握微生物对环境中污染物的降解与转化及环境监测中的微生物学相关方法。此外,也使学生进一步加深理解环境微生物课程的理论知识,培养学生观察,思考及独立分析问题和解决问题的能力,启迪学生的创新思维。
| 课程章节 | | 文件类型 | | 修改时间 | | 大小 | | 备注 | |
| 1.1 24环工1班 |
文档
.docx
|
2025-09-01 | 35.80KB | ||
| 1.2 23环工2班 |
文档
.docx
|
2024-09-10 | 35.47KB | ||
| 1.3 2020环工1班 |
文档
.docx
|
2022-09-11 | 35.37KB | ||
| 1.4 2020环工2班 |
文档
.docx
|
2022-09-11 | 35.41KB | ||
| 1.5 2019环工1班 |
文档
.pdf
|
2022-09-11 | 172.91KB | ||
| 1.6 2019环工2班 |
文档
.doc
|
2022-08-20 | 95.00KB | ||
| 1.7 2018环工1班 |
文档
.pdf
|
2022-09-11 | 170.13KB | ||
| 1.8 2018环工2班 |
文档
.docx
|
2022-09-11 | 34.62KB | ||
| 1.9 2016环工1班 |
文档
.pdf
|
2022-09-11 | 169.12KB | ||
| 2.1 2020环工1班 |
文档
.docx
|
2021-08-29 | 17.50KB | ||
| 2.2 2020环工2班 |
文档
.docx
|
2021-09-08 | 19.67KB | ||
| 2.3 2019环工1班 |
文档
.docx
|
2020-09-01 | 32.02KB | ||
| 2.4 2019环工2班 |
文档
.docx
|
2022-08-20 | 15.43KB | ||
| 2.5 2018环工1班 |
文档
.docx
|
2020-09-01 | 26.44KB | ||
| 2.6 2018环工2班 |
文档
.docx
|
2021-07-22 | 15.46KB | ||
| 2.7 2016环工1班 |
文档
.docx
|
2020-12-23 | 37.58KB | ||
| 2.8 23环工2班-1组 |
表格
.xls
|
2024-09-12 | 29.00KB | ||
| 2.9 23环工2班-2组 |
表格
.xls
|
2024-09-12 | 29.00KB | ||
| 3.1 2019版教学大纲 |
文档
.docx
|
2020-12-24 | 36.42KB | ||
| 3.2 2021版教学大纲 |
文档
.docx
|
2022-08-20 | 47.75KB | ||
| 4.1 实验一 环境工程微生物学实验课程介绍及要求 |
文档
.pdf
|
2021-07-22 | 153.20KB | ||
| 4.2 实验二 光学显微镜的操作及细菌个体形态的观察 |
文档
.pdf
|
2021-07-22 | 157.78KB | ||
| 4.2.1 课后自测题 |
文档
.docx
|
2020-12-24 | 18.86KB | ||
|
文档
.docx
|
2020-12-24 | 672.84KB | |||
| 4.3 实验三 真菌个体形态的观察 |
文档
.pdf
|
2021-07-22 | 64.92KB | ||
| 4.3.1 课后自测题 |
文档
.docx
|
2022-08-09 | 21.89KB | ||
| 4.4 实验四 微生物细胞的计数 |
文档
.pdf
|
2021-07-22 | 92.48KB | ||
| 4.5 实验五 微生物细胞的测量 |
文档
.pdf
|
2021-07-22 | 185.46KB | ||
| 4.5.1 课后自测题 |
文档
.docx
|
2020-10-26 | 16.04KB | ||
| 4.6 实验六 培养基的配制和灭菌 |
文档
.pdf
|
2021-07-22 | 155.54KB | ||
| 4.6.1 课后自测题 |
文档
.docx
|
2020-12-23 | 22.64KB | ||
|
文档
.docx
|
2020-12-23 | 21.31KB | |||
| 4.7 实验七 土壤细菌分离及菌落总数的测定 |
文档
.pdf
|
2021-07-22 | 162.76KB | ||
| 4.7.1 课后自测题 |
文档
.docx
|
2020-10-26 | 18.66KB | ||
|
文档
.docx
|
2020-10-26 | 19.25KB | |||
|
文档
.docx
|
2020-10-26 | 19.03KB | |||
| 4.8 实验八 细菌纯种分离、培养和接种技术 |
文档
.pdf
|
2021-07-22 | 378.93KB | ||
| 4.9 实验九 纯培养菌种的菌体、菌落形态的观察 |
文档
.pdf
|
2021-07-22 | 65.91KB | ||
| 4.9.1 课后自测题 |
文档
.docx
|
2020-10-26 | 16.13KB | ||
| 4.10 实验十 细菌的革兰氏染色 |
文档
.pdf
|
2022-09-21 | 151.85KB | ||
| 4.10.1 课后自测题 |
文档
.docx
|
2022-09-21 | 20.82KB | ||
| 4.11 实验十一 空气中微生物的测定 |
文档
.pdf
|
2021-07-22 | 185.64KB | ||
| 4.12 实验十二 水中大肠杆菌的测定 |
文档
.pdf
|
2021-07-22 | 225.00KB | ||
| 4.12.1 课后自测题 |
文档
.docx
|
2020-10-26 | 351.90KB | ||
| 4.13 实验十三 硝化细菌的分离及活性检测 |
文档
.doc
|
2021-07-22 | 64.50KB | ||
| 4.14 实验十四 活性污泥的镜检分析 |
文档
.pdf
|
2021-07-22 | 96.10KB | ||
| 5.1 实验报告撰写基本格式 |
文档
.docx
|
2022-08-20 | 18.91KB | ||
| 6.1 廖永辉的版本 |
文档
.pptx
|
2022-08-20 | 31.57MB | ||
| 7.1 光学显微镜的使用及原核生物 的个体形态观察 |
文档
.ppt
|
2020-09-01 | 5.20MB | ||
| 7.2 真核微生物的个体形态观察 |
文档
.ppt
|
2020-09-01 | 11.95MB | ||
| 7.3 微生物细胞的计数和测量 |
文档
.ppt
|
2020-09-02 | 630.50KB | ||
| 7.4 细菌的简单染色和革兰氏染色 |
文档
.ppt
|
2020-09-02 | 4.66MB | ||
| 7.5 培养基的配制与灭菌 |
文档
.ppt
|
2020-09-02 | 3.36MB | ||
| 7.6 活性污泥(或土壤)中细菌的纯种 分离和培养 |
文档
.ppt
|
2020-09-01 | 2.33MB | ||
| 7.7 纯培养菌体和菌落形态的观察 |
文档
.ppt
|
2020-09-01 | 2.49MB | ||
| 7.8 河水、生活污水中的生物检测 与水体水质评述 |
文档
.ppt
|
2020-09-02 | 5.08MB | ||
| 8.1 部分仪器的使用 |
视频
.mp4
|
2024-08-03 | 263.20MB | ||
|
视频
.mp4
|
2024-08-03 | 190.99MB | |||
|
视频
.mp4
|
2024-08-03 | 304.91MB | |||
| 8.2 培养基的配置 |
视频
.mp4
|
2024-08-02 | 401.65MB | ||
| 8.3 平板制备 |
视频
.mp4
|
2024-08-04 | 289.32MB | ||
| 8.4 微生物接种 |
视频
.mp4
|
2024-08-04 | 301.11MB | ||
| 8.5 霉菌的观察 |
视频
.mp4
|
2024-08-04 | 199.35MB | ||
| 8.6 霉菌的显微观察 |
视频
.mp4
|
2024-08-04 | 154.82MB | ||
| 8.7 酵母的观察与计数 |
视频
.mp4
|
2024-08-04 | 152.13MB | ||
| 8.8 细菌的培养与染色观察 |
视频
.mp4
|
2024-08-04 | 252.94MB | ||
| 8.9 革兰氏染色 |
视频
.mp4
|
2024-08-04 | 138.61MB | ||
| 9.1 灭菌及显微镜的使用 |
文档
.docx
|
2022-09-21 | 471.77KB | ||
| 9.2 微生物的培养、制片及染色 |
文档
.docx
|
2022-09-21 | 20.41KB |